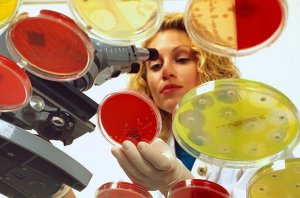
USA Today: устойчивые к антибиотикам бактерии активно распространяются в США

отметили
78
человек
в архиве
«Давно не было такого успеха»: сборная России завоевала пять золотых медалей на Международной математической олимпиаде
 russian.rt.com
russian.rt.com
Выпускники российских школ завоевали пять золотых и одну серебряную медаль на Международной математической олимпиаде в Румынии. В неофициальном зачёте сборная России заняла второе место. Руководитель команды Назар Агаханов в интервью RT рассказал о самих соревнованиях и о подготовке к ним. — Расс...
6 комментариев
проблема (1)
отметили
57
человек
в архиве
Зафиксировано резкое падение рейтинга власти согласно данным опроса, проведенного «Левада-центром».
 znak.com
znak.com
Деятельность Владимира Путина на посту президента РФ одобряют 65% россиян. Еще месяц назад этот показатель был намного выше — 79%.31% опрошенных ответили, что не одобряют деятельность президента. Месяц назад об этом заявили лишь 20% опрошенных.Работу правительства одобрили 34% россиян, 61% респонден...
проблема (3)
отметили
52
человека
в архиве
Создана программа с высокой долей вероятности прогнозирующая болезнь Паркинсона
 ria.ru
ria.ru
Биологи из Санкт-Петербурга разработали программу, которая умеет находить следы болезни Паркинсона и предсказывать ее дальнейшее развитие почти со 100% точностью. О первых итогах ее работы рассказывает пресс-служба «Проекта 5-100».
«Наша программа способна предсказать проявятся ли у пациента опр...
отметили
51
человек
в архиве
Российские химики создали тормоз для наномашин
 ria.ru
ria.ru
Ученые из Института физической химии и электрохимии РАН создали структуру, которая может играть роль своеобразного «тормоза» для наномашин, реагируя на изменения кислотно-щелочного баланса. Инструкции по его сборке были опубликованы в New Journal of Chemistry.
«Почему интересно управлять такой м...
проблема (2)
отметили
51
человек
в архиве
Сибирские ученые обнаружили необъяснимый всплеск углекислого газа в атмосфере
 chrdk.ru
chrdk.ru
Исследователи из Института оптики атмосферы им. В.Е. Зуева Сибирского отделения РАН с помощью летающей лаборатории обнаружили устойчивое, многолетнее повышение концентрации СО2 над территорией Западной Сибири, юго-западнее Новосибирска. Причины всплеска пока неясны — концентрация здесь явно выше, че...
проблема (3)
отметили
51
человек
в архиве
Физики из России создали новый тип "лазерного" оптоволокна
 ria.ru
ria.ru
Физики из РАН разработали новый тип оптоволокна, который можно использовать в качестве базового материала для создания ярких и компактных инфракрасных лазеров. «Рецепт» по его производству был опубликован вJournal of Selected Topics in Quantum Electronics.
«Волоконные лазеры генерируют в оп...
проблема (2)
отметили
37
человек
в архиве
«Святой источник» огня. Бутылка воды в форме футбольного мяча едва не стала причиной пожара в офисе: когда в окна заглянуло солнце, около бутыли появился заметный дымок, запахло паленым ламинатом
 fontanka.ru
fontanka.ru
«Святой источник» выпустил к ЧМ-2018 бутылку воды в форме футбольного мяча, но вмешались законы физики: на солнце, едва удалось избежать пожара.Первые пострадавшие купили новинку и поставили на пол в офисе. Когда в окна конторы заглянуло солнце, около бутыли появился заметный дымок, запахло паленым ...
отметили
55
человек
в архиве
Швейцарские физики впервые разделили воду на две разные жидкости
 mir24.tv
mir24.tv
Физики из Швейцарии впервые в истории науки сумели разделить воду на две разные жидкости, состоящие из двух типов молекул воды. Подробности этого процесса отражены в статье, которая опубликована в издании Nature Communications.«Мы показали, что реакции с участием параводы идут на 25% быстрее, чем с ...
проблема (2)
отметили
63
человека
в архиве
Создан альтернативный ФГС и эндоскопии тест для диагностики рака пищевода и желудка
 scientificrussia.ru
scientificrussia.ru
Результаты первого клинического испытания показали, что точность теста составляет 85%. Он дешевле и приятнее эндоскопии, которую обычно используют для диагностики рака пищевода и желудка. Ученые надеются, что в будущем пациенты будут сдавать тест на дыхание так же, как и обычный анализ крови. О ново...
отметили
39
человек
в архиве
Впервые осуществлена пересадка памяти между живыми существами
 lenta.ru
lenta.ru
Ученые Калифорнийского университета в Лос-Анджелесе осуществили пересадку памяти от одной морской улитки к другой через инъекцию специфических рибонуклеиновых кислот (РНК). Статья исследователей опубликована в журнале eNeuro, сообщает EurekAlert!.Ученые подвергали моллюсков рода Aplysia слабому возд...
проблема (1)
отметили
54
человека
в архиве
Лазер за миллиард: зачем Россия вкладывается в научные мегапроекты
2 ria.ru
ria.ru
Успешное строительство рентгеновского лазера на свободных электронах — XFEL — вызвало интерес во всем мире. Мало кто знает, что у этого проекта российские корни. XFEL сможет фотографировать структуры размером меньше нанометра и тем самым решать множество практических задач для биологии, химии, медиц...
проблема (1)
отметили
46
человек
в архиве
Учёные из США разработали полимер, обладающий всеми полезными свойствами пластика, при этом его можно легко разрушить, а затем переработать
 vesti.ru
vesti.ru
Пластмассы в массы: сегодня этот дешёвый, лёгкий и «долгоживущий» материал используют всюду. Правда, хрупкие полимерные изделия, как правило, долго живут не в домах людей, а на мусорных свалках. И сегодня экологи всерьёз заявляют о глобальной угрозе, вызванной чрезмерным использованием пластика. Одн...
отметили
57
человек
в архиве
Биологи из России научились включать «починку ДНК» в раковых клетках
 rus.vrw.ru
rus.vrw.ru
Ученые из Санкт-Петербурга создали лекарство, принудительно заставляющее раковые клетки начать чинить свою ДНК и самоуничтожаться при фатальном повреждении генома, говорится в статьях, опубликованных в журналах Chirality и Bioorganic & Medicinal Chemistry Letters.«Мы завершили эксперименты с новым к...
проблема (1)
отметили
35
человек
в архиве
Древнейший идол России оказался старше Черного моря
 chrdk.ru
chrdk.ru
Деревянная фигура застала мезолит — средний каменный век и оказалась старейшей из больших сохранившихся скульптур человечества.Международная группа исследователей при участии российских ученых провела радиоуглеродную датировку Большого Шигирского идола, хранящегося в Свердловском краеведческом музее...
проблема (3)
отметили
44
человека
в архиве
Знакомьтесь: новая российская база «Северный полюс» thebarentsobserver.com
thebarentsobserver.com/sites/default/files/styles/full_width/public/platformnorthpole-admship.jpgАО «Адмиралтейские верфи» подписало контракт с Федеральной службой по гидрометеорологии и мониторингу окружающей среды (Росгидромет) на проектирование и строительство ледостойкой самодвижущейся платформы...
проблема (1)
отметили
57
человек
в архиве
Опрос: действия Мэй в ситуации с Сирией поддерживают 28% британцев, 36% респондентов высказались против, 26% не смогли определиться с ответом
 russian.rt.com
russian.rt.com
По данным опроса, проведённого BMG Research в Великобритании, решение премьер-министра страны Терезы Мэй нанести удар по Сирии поддерживают лишь 28% подданных. Об этом сообщает The Independent.Отмечается, что 36% респондентов высказались против, между тем 26% опрошенных не смогли определиться с отве...
проблема (1)
отметили
56
человек
в архиве
DWN: «Главную ответственность» за рост напряжённости в отношениях между Западом и Россией половина немцев возложила на США. 55% немцев высказались за постепенную отмену экономических санкций против РФ
 russian.rt.com
russian.rt.com
Согласно последнему опросу, «главную ответственность» за рост напряжённости в отношениях между Западом и Россией половина немцев возложила на Соединённые Штаты, сообщает Deutsche Wirtschafts Nachrichten. Как отмечает издание, лишь четверть жителей Германии винит в происходящем Российскую Федерацию.
...
проблема (1)
отметили
48
человек
в архиве
Фундаментальный приоритет (Бюджетные расходы на науку необходимо увеличить в полтора раза, заявил Владимир Путин)
 iz.ru
iz.ru
Президент России Владимир Путин призвал увеличить финансирование науки в полтора раза и повысить эффективность использования этих средств. Деньги должны получать те организации, которые добиваются конкретных результатов, заявил глава государства на совместном заседании президиума Российской академии...
проблема (1)
отметили
48
человек
в архиве
Ученые: Клетки мозга восстанавливаются даже у самых пожилых людей
 rg.ru
rg.ru
Специалисты из Колумбийского университета в Нью-Йорке (США) обнаружили, что в гиппокампе людей преклонного возраста формируются десятки тысяч новых нейронов точно так же, как и в мозге молодежи. Статья об этом опубликована в научном журнале Cell Stem Cell.По словам Мауры Болдрини (Maura Boldrini) из...
отметили
68
человек
в архиве
[История] 5 апреля 1242 года произошла битва на Чудском озере (Ледовое побоище)
 odigitria.by
odigitria.by
Эта битва всеми однозначно воспринимается как героическая, справедливая, можно даже сказать образцово Христианская. Поэтому как-бы особо не о чем тут говорить, события всем известны и даже в советских учебниках о ней в принципе всё достаточно корректно было сказано. Единственное, что не говорилось, ...
проблема (2)
отметили
43
человека
в архиве
USA Today: устойчивые к антибиотикам бактерии активно распространяются в США
 tass.ru
tass.ru
Согласно исследованиям, в 2017 году в США зафиксированы более 220 случаев обнаружения различных разновидностей «кошмарной бактерии»
Устойчивая к воздействию практически любых лекарственных средств группа микроогранизмов, именуемая из-за этого «кошмарной», получает более широкое распро...
проблема (3)
отметили
57
человек
в архиве
Академик РАН: Из отходов можно получить доход в 130 млрд долларов. Отходы - это не мусор, который надо уничтожать, а богатство, но его надо уметь взять
 rg.ru
rg.ru
Какие проекты по борьбе с отходами есть в портфеле Российской академии наук? Об этом корреспондент «РГ» беседует с академиком РАН Леопольдом Леонтьевым.В одном из интервью, отвечая на вопрос об острейшей ситуации со свалками, президент РАН Александр Сергеев сказал, что решение есть, и сослался на ра...
отметили
59
человек
в архиве
Ученые из России создали терагерцовый "лазер", разрушающий металл
 ria.ru
ria.ru
Физики из Российской академии наук создали генератор Т-лучей, способных разрушать металлические конструкции и проверили его в деле, говорится в статье, опубликованной в журнале Physical Review Letters.
Терагерцовое излучение относится к числу самых перспективных направлений исследований в ...
отметили
38
человек
в архиве
Международная группа ученых исследует фермент «бессмертия и старения»
 gazeta.ru
gazeta.ru
Сотрудники МГУ имени М.В. Ломоносова в составе международного коллектива исследователей идентифицировали структуру одного из ключевых участков теломеразы — фермента клеточного бессмертия. Изучение строения этого белка имеет особое значение при разработке препаратов, направленных на лечение рака. Рез...
отметили
98
человек
в архиве
Умер Стивен Хокинг
 ria.ru
ria.ru
Всемирно известный английский физик-теоретик Стивен Уильям Хокинг скончался на 77 году жизни, сообщает телеканал BBC со ссылкой на представителя семьи.Хокинг — физик-теоретик, известный популяризатор науки и автор книги «Краткая история времени», которая разошлась 10-миллионным тиражом. Он занимался...

















![[История] 5 апреля 1242 года произошла битва на Чудском озере (Ледовое побоище)](/story_images/543000/1522915622_95_image.jpg)
_d_850.jpg)



